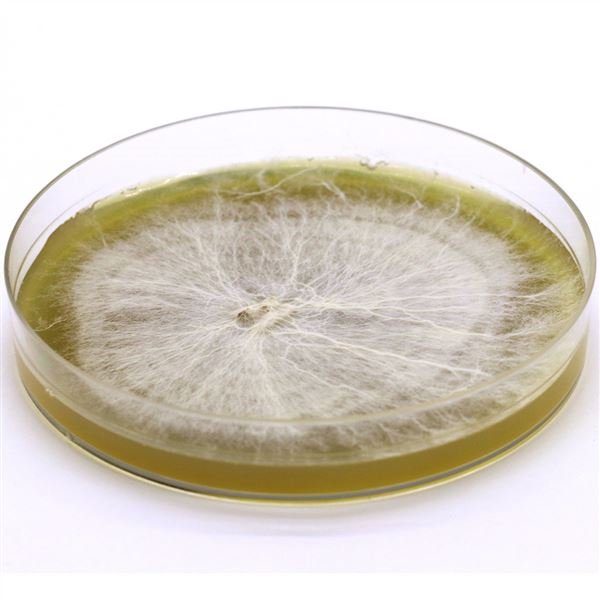
ریسه تجاری قارچ خوراکی قهوه ای

صنایع غذایی پیشتاز رازک
شرکت صنایع غذایی پیشتاز رازک(بسته بندی ملارد) در تاریخ : 1359/06/12 با عنوان لوئی موند در شهر تهران با هدف تولید انواع مواد غذایی مجاز و صادرات و واردات مربوط ...
وب سایت : -
رضوان شکلات
شرکت رضوان شکلات با هدف ارائه بهترین خدمت به مشتریان و مصرف کنندگان ارجمند ایرانی، با بهره گیری از مواد اولیه مرغوب، تکنولوژی تولید کارآمد، سرمایه های انسانی به ...
وب سایت : -
شیرین عسل
گروه صنايع غذايي شيرين عسل تنها گروه صنعتي متشكل در زمينه توليد انواع شيريني و شكلات و محصولات كاكائو مي باشد كه محصولات متنوع و مرغوبي را براي قشر وسيعي از مص ...
وب سایت : -
صنایع غذایی بیژن
امروز این واحد خوشنام از جایگاهی شایسته در صنایع غذایی کشور برخوردار می باشد و به عنوان یک گروه صنعتی با سه زیر مجموعه در زمینههای مستقل اما مرتبط، فعالیت گستر ...
وب سایت : http://bijanfood.com
بیک صنعت
شرکت بیک صنعت (سهامی خاص) درسال 1373 با هدف تجهیز واحدهای تولید نان حجیم، قنادی و شکلات سازی به ماشین آلات و تجهیزات روزآمد دنیا تأسیس گردید . هم اکنون بیک صنعت ...
وب سایت : -
گروه صنایع غذایی فافا
گروه صنایع غذایی فافا (سهامی خاص) سال 1365 در شهر نیشابور با تأکید بر تولید محصولات سالم و با کیفیت مطلوب درعرصه تولید محصولات غذایی آغاز به کار نمود. فعالیت مس ...
وب سایت : -
کالا کودک طوس
تاریخچه بی بی لند معتبرترین نام تجاری کودک در ایران است که تلاش برای بهبود شیوه نگهداری و مراقبت از کودک با آخرین تکنولوژی و فن آوری های روز دنیا را با تولید و ...
وب سایت : -
گلان
شرکت گلان یکی از شرکت های تولید کننده لوازم آرایشی و بهداشتی در ایران است که محصولات آرایشی و بهداشتی، پاک کننده و شوینده , همچنین مواد اولیه مرتبط را تولید می ...
وب سایت : -
پاکسان
شرکت پاکسان تولید کننده مواد شوینده بهداشتی و صنعتی در ایران است که با بهره گیری از فناوری روز دنیا و با بکارگیری متخصصین و مهندسین مجرب، هم اکنون به عنوان یکی ...
وب سایت : -
پارس حیات
تاسیس کارخانهای در زمینی به مساحت 240000 متر مربع در شهر ابهر از توابع استان زنجان کرد. در حال حاضر شرکت پارس حیات Iعالیت خود را در بازار ایران با تولید محصول ...
وب سایت : -
صنایع غذایی و بسته بندی خزر خوشه
صنایع غذایی و بسته بندی خزر خوشه (قدس سابق)، با تلاش و همیاری کارشناسان متخصص در خطه سرسبز مازندران، در زمینی به مساحت 6000 مترمربع احداث شده با هدف عرضه هر چه ...
وب سایت : -
مجتمع کشت و صنعت ملارد
شرکت کشت و صنعت ملارد از پیشرفته ترین و مجهز ترین مراکز تولید قارچ تازه و کنسرو قارچ در ایران می باشد که بخش عمده بازار فروش قارچ کشور را در اختیار دارد.
ساخ ...
وب سایت : -
شکوفا بهداشت آرین
شرکت شکوفا بهداشت آرین در سال 1381 با هدف تولید محصولات بهداشتی با توان رقابت کیفی با کالاهای نامدار خارجی و داخلی در بازارهای داخلی و بین المللی با حفظ حقوق م ...
وب سایت : -
صنعتی و بازرگانی صحت
شرکت صنعتی و بازرگانی صحت درسال ١٣٣٥ در تهران تاسيس شد. به گواهی دفتر صنایع غذایی، دارویی و بهداشتی ایران، این شرکت اولین تولید کننده شامپوهای گیاهی در کشور است ...
وب سایت : -
گروه صنعتی رازی
گروه صنعتی رازی در سال 1359 پایه ریزی شد و این ایده ابتدا با تشکیل شرکت شیمیایی رازی برای تولید انواع چسب های صنعتی و خانگی شکل گرفت که در سال 1361 به تولید رسی ...
وب سایت : -
ترش افروز پاک
شرکت ترش افروز پاک محصولات خود را با نام تجاری “جنگلی” تحت نظارت متخصصان مجرب صنایع غذايی و کارشناسان وزارت بهداشت بوسيله دستگاه های مدرن، تمام اتوماتيک و تمام ...
وب سایت : -
زرین جم مارینا
شرکت زرین جم مارینا در سال 1387 تاسیس گردید و با راه اندازی کارخانه ای به مساحت بیش از صدهزار متر مربع در شهر صنعتی کاوه در سال 1391 به بهره برداری رسید. این ش ...
وب سایت : -
ماشین سازی مرشد گوهر
نان حجیم در ایران از اوایل دهه 50 به سفره های مردم راه پیدا کرد . در آن زمان تعداد انگشت شماری از این واحدهای تولید نان در تهران با ماشین آلات خارجی تاسیس شد لی ...
وب سایت : -
نبوغ تجارت ایرانیان
شرکت بازرگانی نبوغ تجارت ایرانیان به عنوان بزرگترین تامین کننده سفارشات بازرگانی اعم از داخلی و صادرات از سال 1402 فعالیت خود را به صورت رسمی آغاز کرد
ارتباط ...
وب سایت : https://www.akpsho.com/shopview/23388
یونیلیور ایران
با تاسیس شرکت و شروع فعالیتهای آن از بیش از 100 سال پیش، ما یکی از بزرگترین شرکتهای تولیدکننده کالاهای مصرفی هستیم. شهرت ما مرهون برندهای منحصربهفرد، فعالیت ...
وب سایت : https://www.akpsho.com/shopview/23478
شرکت هنکل پاکوش
هنکل پاکوش یک شرکت سهامی عام ایرانی تولیدکنندهٔ مواد شوینده است، که در سال 1357 تأسیس شدهاست.
این شرکت که در شهرک صنعتی کاوه قرار دارد، در ابتدا با نام «پا ...
وب سایت : https://www.akpsho.com/shopview/10807
حمل و نقل بین المللی بهروش سریع
شرکت حمل و نقل بین المللی بهروش سریع به شماره ثبت 129345 دارای مجوز رسمی از وزارت راه و ترابری و گمرک ایران در سال 1376/1/17 تاسیس و فعالیت خود را در زمینه حمل ...
وب سایت : http://www.behraveshsarie.com/
گروه بهداشتی فیروز
گروه بهداشتی فیروز در سال 1353 با مشارکت شرکت جانسون اند جانسون آمریکا به عنوان اولین تولید کننده محصولات بهداشتی کودک در خاورمیانه آغاز به کارکرد و امروز پس از ...
وب سایت : http://www.firooz.com
صنایع آرایشی بهداشتی اژه فام قزوین
شركت صنایع آرایشی و بهداشتی اژه فام در تاریخ 1377 در شهرك صنعتی لیا واقع در 14 كیلومتری شهر قزوین با هدف تولید انواع صابونهای گلیسیرینه (شفاف) تاسیس و در سال 13 ...
وب سایت : http://www.ejefam.ir/
هنر آسمان و زمین
به نام بزرگ طراح و سازنده خوش ذوق جهان هستی ، او آفریننده ی هرچیزی است و خودش برهمه چیز نگهبان است آیه 62 سوره زمر : اللَّهُ خَالِقُ کُلَّ شَیْءٍ وَهُوَ عَلَى ک ...
وب سایت : https://letkashop.com/
صنایع آرایشی بهداشتی پاک تز
شرکت آرایشی و بهداشتی پاک تز و اژه فام (صابون سازی یوسفی) کارخانه صابون سازی یوسفی در سال 1287 شمسی در تبریز فعالیت خود را با تولید صابونهای رختشویی به نام آذرب ...
وب سایت : http://paktez.com/